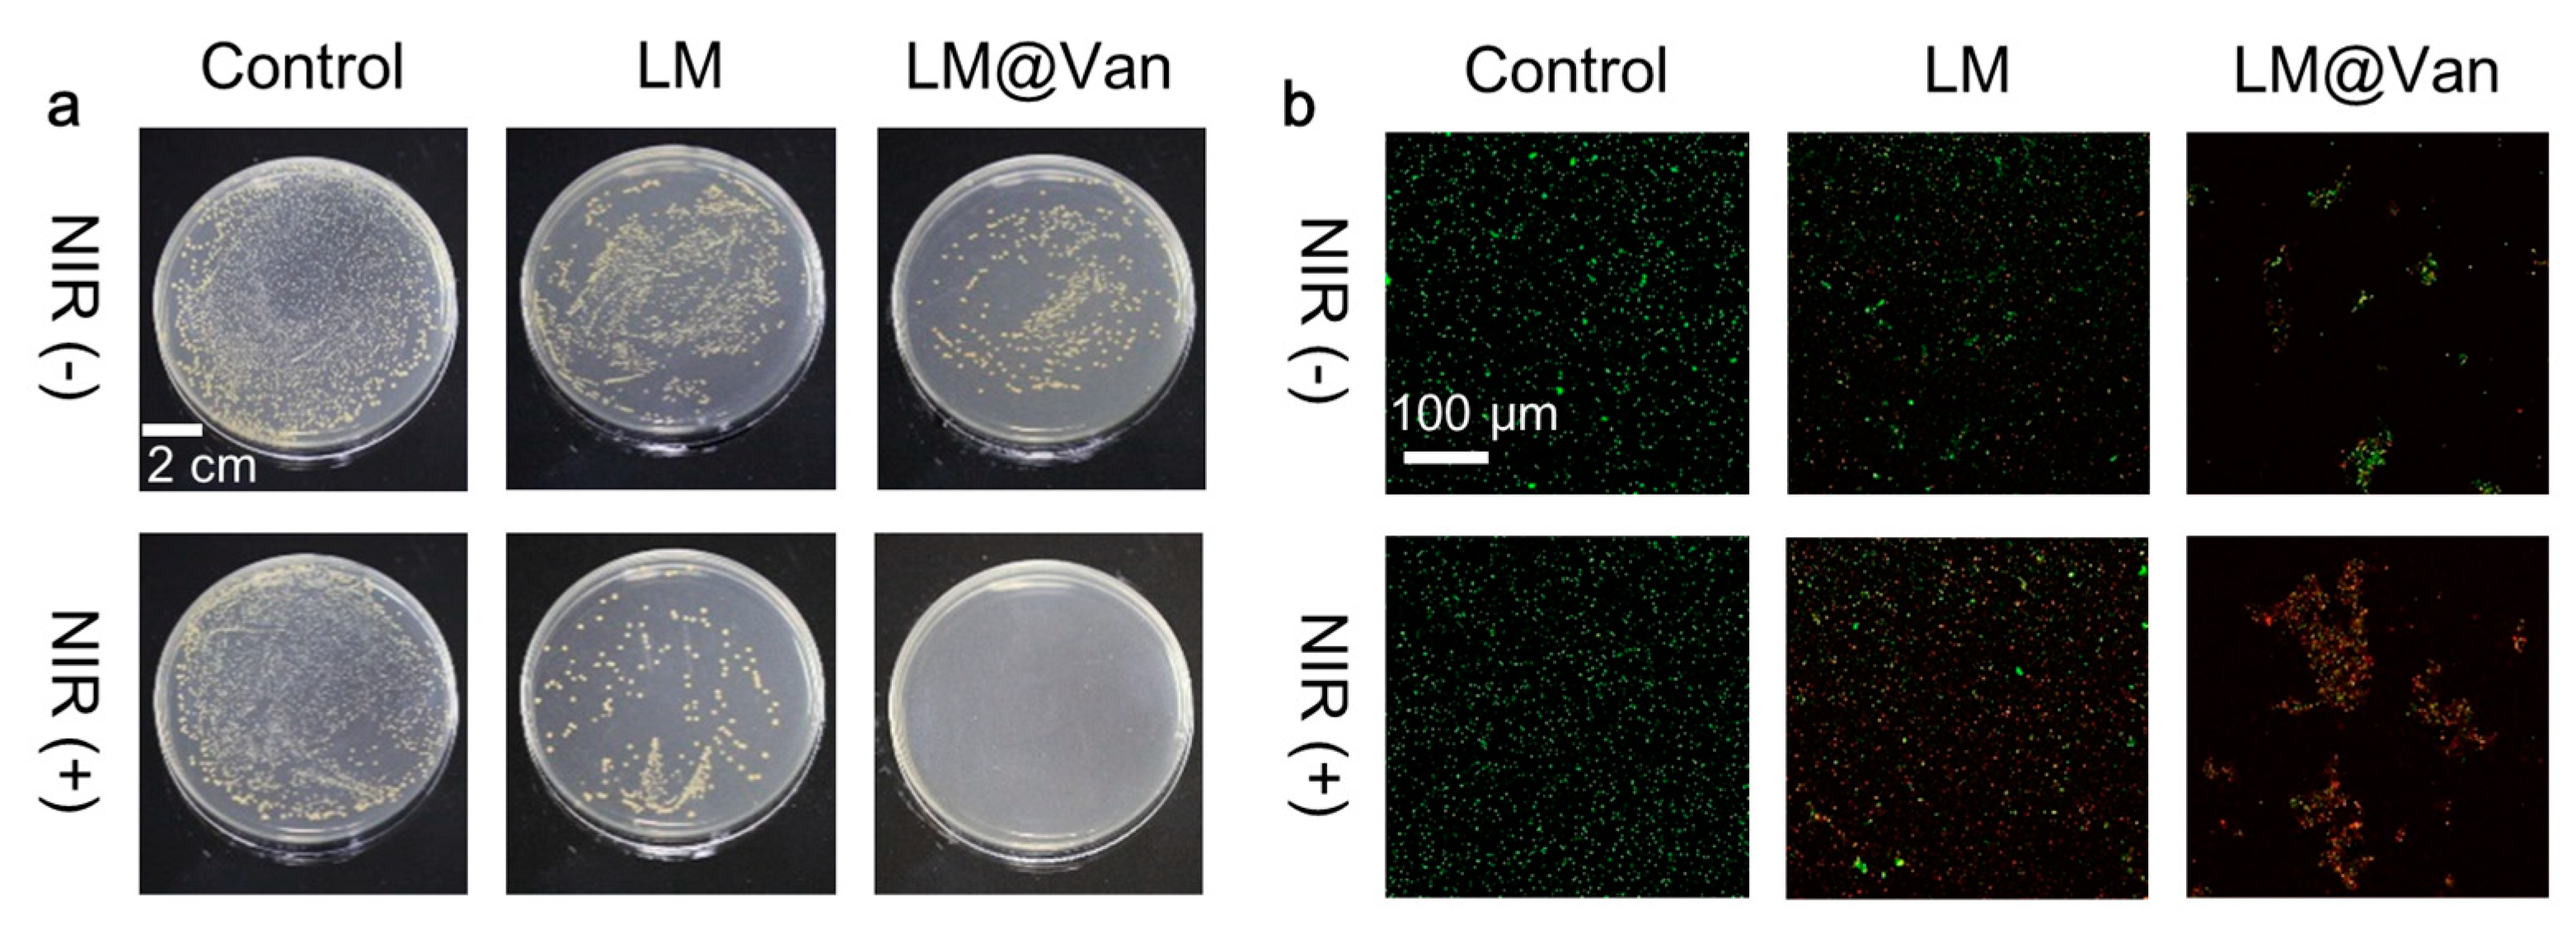
Bioengineering 10 00748 g005 Bioengineering 10 00748 g005

A Photothermally Enhanced Vancomycin-Coated Liquid Metal Antimicrobial Agent with Targeting Capability
Abstract
1. Introduction
2. Materials and Methods
2.1. Materials
2.2. Synthesis of LM and LM@Van
2.3. Characterization of LM and LM@Van
2.4. Photothermal Effect of LM and LM@Van
2.5. Bacterial Culture and Antibacterial Evaluation In Vitro
2.6. Live/Dead Staining
2.7. Bacterial Morphological Characterization
2.8. Cytotoxicity Testing In Vitro
3. Results and Discussion
4. Conclusions
Supplementary Materials
Author Contributions
Funding
Institutional Review Board Statement
Informed Consent Statement
Data Availability Statement
Acknowledgments
Conflicts of Interest
References
- Hubbard, B.K.; Walsh, C.T. Vancomycin Assembly: Nature’s Way. Angew. Chem. Int. Ed. 2003, 42, 730–765. [Google Scholar] [CrossRef]
- Rybak, M.J.; Le, J.; Lodise, T.P.; Levine, D.P.; Bradley, J.S.; Liu, C.; Mueller, B.A.; Pai, M.P.; Wong-Beringer, A.; Rotschafer, J.C.; et al. Therapeutic Monitoring of Vancomycin for Serious Methicillin-Resistant Staphylococcus Aureus Infections: A Revised Consensus Guideline and Review by the American Society of Health-System Pharmacists, the Infectious Diseases Society of America, the Pediatric Infectious Diseases Society, and the Society of Infectious Diseases Pharmacists. Clin. Infect. Dis. 2020, 71, 1361–1364. [Google Scholar] [CrossRef] [PubMed]
- Rybak, M.J.; Le, J.; Lodise, T.P.; Levine, D.P.; Bradley, J.S.; Liu, C.; Mueller, B.A.; Pai, M.P.; Wong-Beringer, A.; Rotschafer, J.C.; et al. Therapeutic Monitoring of Vancomycin for Serious Methicillin-Resistant Staphylococcus Aureus Infections: A Revised Consensus Guideline and Review by the American Society of Health-System Pharmacists, the Infectious Diseases Society of America, the Pediatric Infectious Diseases Society, and the Society of Infectious Diseases Pharmacists. Am. J. Health-Syst. Pharm. 2020, 77, 835–864. [Google Scholar] [CrossRef] [PubMed]
- Lopez-Iglesias, C.; Barros, J.; Ardao, I.; Monteiro, F.J.; Alvarez-Lorenzo, C.; Gomez-Amoza, J.L.; Garcia-Gonzalez, C.A. Vancomycin-Loaded Chitosan Aerogel Particles for Chronic Wound Applications. Carbohydr. Polym. 2019, 204, 223–231. [Google Scholar] [CrossRef]
- Appelbaum, P.C. The Emergence of Vancomycin-Intermediate and Vancomycin-Resistant Staphylococcus Aureus. Clin. Microbiol. Infect. 2006, 12, 16–23. [Google Scholar] [CrossRef]
- Boger, D.L. Vancomycin, Teicoplanin, and Ramoplanin: Synthetic and Mechanistic Studies. Med. Res. Rev. 2001, 21, 356–381. [Google Scholar] [CrossRef] [PubMed]
- Cosgrove, S.E.; Carroll, K.C.; Perl, T.M. Staphylococcus Aureus with Reduced Susceptibility to Vancomycin. Clin. Infect. Dis. 2004, 39, 539–545. [Google Scholar] [CrossRef]
- Zhang, W.; Ye, G.; Liao, D.; Chen, X.; Lu, C.; Nezamzadeh-Ejhieh, A.; Khan, M.S.; Liu, J.; Pan, Y.; Dai, Z. Recent Advances of Silver-Based Coordination Polymers on Antibacterial Applications. Molecules 2022, 27, 7166. [Google Scholar] [CrossRef]
- Zeng, Y.; Xu, G.; Kong, X.; Ye, G.; Guo, J.; Lu, C.; Nezamzadeh-Ejhieh, A.; Khan, M.S.; Liu, J.; Peng, Y. Recent Advances of the Core-Shell Mofs in Tumour Therapy. Int. J. Pharm. 2022, 627, 122228. [Google Scholar] [CrossRef]
- Chen, J.; Cheng, F.; Luo, D.; Huang, J.; Ouyang, J.; Nezamzadeh-Ejhieh, A.; Khan, M.S.; Liu, J.; Peng, Y. Recent Advances in Ti-Based Mofs in Biomedical Applications. Dalton Trans. 2022, 51, 14817–14832. [Google Scholar] [CrossRef]
- Zheng, R.; Guo, J.; Cai, X.; Bin, L.; Lu, C.; Singh, A.; Trivedi, M.; Kumar, A.; Liu, J. Manganese Complexes and Manganese-Based Metal-Organic Frameworks as Contrast Agents in Mri and Chemotherapeutics Agents: Applications and Prospects. Colloids Surf. B Biointerfaces 2022, 213, 112432. [Google Scholar] [CrossRef]
- Walsh, C. Microbiology—Deconstructing Vancomycin. Science 1999, 284, 442–443. [Google Scholar] [CrossRef]
- Rice, L.B. Emergence of Vancomycin-Resistant Enterococci. Emerg. Infect. Dis. 2001, 7, 183–187. [Google Scholar] [CrossRef]
- Tenover, F.C.; Biddle, J.W.; Lancaster, M.V. Increasing Resistance to Vancomycin and Other Glycopeptides in Staphylococcus Aureus. Emerg. Infect. Dis. 2001, 7, 327–332. [Google Scholar] [CrossRef]
- Cong, Y.; Yang, S.; Rao, X. Vancomycin Resistant Staphylococcus Aureus Infections: A Review of Case Updating and Clinical Features. J. Adv. Res. 2020, 21, 169–176. [Google Scholar] [CrossRef] [PubMed]
- Kim, S.G.; Becattini, S.; Moody, T.U.; Shliaha, P.V.; Littmann, E.R.; Seok, R.; Gjonbalaj, M.; Eaton, V.; Fontana, E.; Amoretti, L.; et al. Microbiota-Derived Lantibiotic Restores Resistance against Vancomycin-Resistant Enterococcus. Nature 2019, 572, 665–669. [Google Scholar] [CrossRef]
- Cetinkaya, Y.; Falk, P.; Mayhall, C.G. Vancomycin-Resistant Enterococci. Clin. Microbiol. Rev. 2000, 13, 686–707. [Google Scholar] [CrossRef]
- McGuinness, W.A.; Malachowa, N.; DeLeo, F.R. Vancomycin Resistance in Staphylococcus Aureus. Yale J. Biol. Med. 2017, 90, 269–281. [Google Scholar] [PubMed]
- Chen, S.; Zhao, R.; Sun, X.; Wang, H.; Li, L.; Liu, J. Toxicity and Biocompatibility of Liquid Metals. Adv. Healthc. Mater. 2022, 12, 2201924. [Google Scholar] [CrossRef]
- Chen, S.; Wang, H.-Z.; Zhao, R.-Q.; Rao, W.; Liu, J. Liquid Metal Composites. Matter 2020, 2, 1446–1480. [Google Scholar] [CrossRef]
- Ma, K.; Liu, J. Liquid Metal Cooling in Thermal Management of Computer Chips. Front. Energy Power Eng. China 2007, 1, 384–402. [Google Scholar] [CrossRef]
- Li, G.; Zhang, M.; Liu, S.; Yuan, M.; Wu, J.; Yu, M.; Teng, L.; Xu, Z.; Guo, J.; Li, G.; et al. Three-Dimensional Flexible Electronics Using Solidified Liquid Metal with Regulated Plasticity. Nat. Electron. 2023, 6, 154–163. [Google Scholar] [CrossRef]
- Lee, W.; Kim, H.; Kang, I.; Park, H.; Jung, J.; Lee, H.; Park, H.; Park, J.S.; Yuk, J.M.; Ryu, S.; et al. Universal Assembly of Liquid Metal Particles in Polymers Enables Elastic Printed Circuit Board. Science 2022, 378, 637–641. [Google Scholar] [CrossRef]
- Jiang, M.; Chen, S.; Zhang, P.; Sun, Y.; Ye, J.; Deng, Y.; Li, L.; Liu, J. Liquid Metal Enabled Plant Injectable Electronics. Mater. Today 2023, 66, 50–61. [Google Scholar] [CrossRef]
- Chen, S.; Wang, H.-Z.; Liu, T.-Y.; Liu, J. Liquid Metal Smart Materials toward Soft Robotics. Adv. Intell. Syst. 2023, 2200375. [Google Scholar] [CrossRef]
- Yan, J.; Lu, Y.; Chen, G.; Yang, M.; Gu, Z. Advances in Liquid Metals for Biomedical Applications. Chem. Soc. Rev. 2018, 47, 2518–2533. [Google Scholar] [CrossRef] [PubMed]
- Liu, R.; Gong, L.; Zhu, X.; Zhu, S.; Wu, X.; Xue, T.; Yan, L.; Du, J.; Gu, Z. Transformable Gallium-Based Liquid Metal Nanoparticles for Tumor Radiotherapy Sensitization. Adv. Healthc. Mater. 2022, 11, e2102584. [Google Scholar] [CrossRef]
- Sun, X.; Cui, B.; Yuan, B.; Wang, X.; Fan, L.; Yu, D.; He, Z.; Sheng, L.; Liu, J.; Lu, J. Liquid Metal Microparticles Phase Change Medicated Mechanical Destruction for Enhanced Tumor Cryoablation and Dual-Mode Imaging. Adv. Funct. Mater. 2020, 30, 2003359. [Google Scholar] [CrossRef]
- Chechetka, S.A.; Yu, Y.; Zhen, X.; Pramanik, M.; Pu, K.; Miyako, E. Light-Driven Liquid Metal Nanotransformers for Biomedical Theranostics. Nat. Commun. 2017, 8, 15432. [Google Scholar] [CrossRef] [PubMed]
- Xie, W.; Allioux, F.-M.; Ou, J.Z.; Miyako, E.; Tang, S.-Y.; Kalantar-Zadeh, K. Gallium-Based Liquid Metal Particles for Therapeutics. Trends Biotechnol. 2021, 39, 624–640. [Google Scholar] [CrossRef] [PubMed]
- Gao, W.; Wang, Y.; Wang, Q.; Ma, G.; Liu, J. Liquid Metal Biomaterials for Biomedical Imaging. J. Mater. Chem. B 2022, 10, 829–842. [Google Scholar] [CrossRef] [PubMed]
- Nan, K.; Babaee, S.; Chan, W.W.; Kuosmanen, J.L.P.; Feig, V.R.; Luo, Y.; Srinivasan, S.S.; Patterson, C.M.; Jebran, A.M.; Traverso, G. Low-Cost Gastrointestinal Manometry Via Silicone-Liquid-Metal Pressure Transducers Resembling a Quipu. Nat. Biomed. Eng. 2022, 6, 1092–1104. [Google Scholar] [CrossRef]
- Park, Y.G.; Lee, G.Y.; Jang, J.; Yun, S.M.; Kim, E.; Park, J.U. Liquid Metal-Based Soft Electronics for Wearable Healthcare. Adv. Healthc. Mater. 2021, 10, e2002280. [Google Scholar] [CrossRef] [PubMed]
- Qu, C.C.; Liang, Y.T.; Wang, X.Q.; Gao, S.; He, Z.Z.; Sun, X.Y. Gallium-Based Liquid Metal Materials for Antimicrobial Applications. Bioengineering 2022, 9, 416. [Google Scholar] [CrossRef] [PubMed]
- Xie, T.; Qi, Y.; Li, Y.; Zhang, F.; Li, W.; Zhong, D.; Tang, Z.; Zhou, M. Ultrasmall Ga-Icg Nanoparticles Based Gallium Ion/Photodynamic Synergistic Therapy to Eradicate Biofilms and against Drug-Resistant Bacterial Liver Abscess. Bioact. Mater. 2021, 6, 3812–3823. [Google Scholar] [CrossRef]
- Elbourne, A.; Cheeseman, S.; Atkin, P.; Truong, N.P.; Syed, N.; Zavabeti, A.; Mohiuddin, M.; Esrafilzadeh, D.; Cozzolino, D.; McConville, C.F.; et al. Antibacterial Liquid Metals: Biofilm Treatment Via Magnetic Activation. ACS Nano 2020, 14, 802–817. [Google Scholar] [CrossRef] [PubMed]
- Goss, C.H.; Kaneko, Y.; Khuu, L.; Anderson, G.D.; Ravishankar, S.; Aitken, M.L.; Lechtzin, N.; Zhou, G.; Czyz, D.M.; McLean, K.; et al. Gallium Disrupts Bacterial Iron Metabolism and Has Therapeutic Effects in Mice and Humans with Lung Infections. Sci. Transl. Med. 2018, 10, eaat7520. [Google Scholar] [CrossRef]
- Emery, T. Exchange of Iron by Gallium in Siderophores. Biochemistry 1986, 25, 4629–4633. [Google Scholar] [CrossRef]
- Crunkhorn, S. Gallium Fights Infection in Phase I Trial. Nat. Rev. Drug Discov. 2018, 17, 786. [Google Scholar] [CrossRef]
- Rangel-Vega, A.; Bernstein, L.R.; Mandujano-Tinoco, E.A.; Garcia-Contreras, S.J.; Garcia-Contreras, R. Drug Repurposing as an Alternative for the Treatment of Recalcitrant Bacterial Infections. Front. Microbiol. 2015, 6, 282. [Google Scholar] [CrossRef]
- Guo, Z.; Lu, J.; Wang, D.; Xie, W.; Chi, Y.; Xu, J.; Takuya, N.; Zhang, J.; Xu, W.; Gao, F.; et al. Galvanic Replacement Reaction for in Situ Fabrication of Litchi-Shaped Heterogeneous Liquid Metal-Au Nano-Composite for Radio-Photothermal Cancer Therapy. Bioact. Mater. 2021, 6, 602–612. [Google Scholar] [CrossRef] [PubMed]
- Yang, N.; Gong, F.; Zhou, Y.; Hao, Y.; Dong, Z.; Lei, H.; Zhong, L.; Yang, X.; Wang, X.; Zhao, Y.; et al. A General in-Situ Reduction Method to Prepare Core-Shell Liquid-Metal / Metal Nanoparticles for Photothermally Enhanced Catalytic Cancer Therapy. Biomaterials 2021, 277, 121125. [Google Scholar] [CrossRef]
- Hu, J.-J.; Liu, M.-D.; Gao, F.; Chen, Y.; Peng, S.-Y.; Li, Z.-H.; Cheng, H.; Zhang, X.-Z. Photo-Controlled Liquid Metal Nanoparticle-Enzyme for Starvation/Photothermal Therapy of Tumor by Win-Win Cooperation. Biomaterials 2019, 217, 119303. [Google Scholar] [CrossRef]
- Yan, J.; Zhang, X.; Liu, Y.; Ye, Y.; Yu, J.; Chen, Q.; Wang, J.; Zhang, Y.; Hu, Q.; Kang, Y.; et al. Shape-Controlled Synthesis of Liquid Metal Nanodroplets for Photothermal Therapy. Nano Res. 2019, 12, 1313–1320. [Google Scholar] [CrossRef]
- Wang, X.L.; Yao, W.H.; Guo, R.; Yang, X.H.; Tang, J.B.; Zhang, J.; Gao, W.P.; Timchenko, V.; Liu, J. Soft and Moldable Mg-Doped Liquid Metal for Conformable Skin Tumor Photothermal Therapy. Adv. Healthc. Mater. 2018, 7, 1800318. [Google Scholar] [CrossRef]
- Mostafavi, E.; Zarepour, A.; Barabadi, H.; Zarrabi, A.; Truong, L.B.; Medina-Cruz, D. Antineoplastic Activity of Biogenic Silver and Gold Nanoparticles to Combat Leukemia: Beginning a New Era in Cancer Theragnostic. Biotechnol. Rep. 2022, 34, e00714. [Google Scholar] [CrossRef]
- Virmani, I.; Sasi, C.; Priyadarshini, E.; Kumar, R.; Sharma, S.K.; Singh, G.P.; Pachwarya, R.B.; Paulraj, R.; Barabadi, H.; Saravanan, M.; et al. Comparative Anticancer Potential of Biologically and Chemically Synthesized Gold Nanoparticles. J. Clust. Sci. 2020, 31, 867–876. [Google Scholar] [CrossRef]
- Ivanoff, C.S.; Ivanoff, A.E.; Hottel, T.L. Gallium Poisoning: A Rare Case Report. Food Chem. Toxicol. 2012, 50, 212–215. [Google Scholar] [CrossRef]

Disclaimer/Publisher’s Note: The statements, opinions and data contained in all publications are solely those of the individual author(s) and contributor(s) and not of MDPI and/or the editor(s). MDPI and/or the editor(s) disclaim responsibility for any injury to people or property resulting from any ideas, methods, instructions or products referred to in the content. |
© 2023 by the authors. Licensee MDPI, Basel, Switzerland. This article is an open access article distributed under the terms and conditions of the Creative Commons Attribution (CC BY) license (https://creativecommons.org/licenses/by/4.0/).
Share and Cite
Wang, B.; Chen, S.; Sun, X.; Shan, X.; Zhu, X.; Yuan, B.; Wang, H.; Zhou, G.; Liu, J. A Photothermally Enhanced Vancomycin-Coated Liquid Metal Antimicrobial Agent with Targeting Capability. Bioengineering 2023, 10, 748. https://doi.org/10.3390/bioengineering10070748
Wang B, Chen S, Sun X, Shan X, Zhu X, Yuan B, Wang H, Zhou G, Liu J. A Photothermally Enhanced Vancomycin-Coated Liquid Metal Antimicrobial Agent with Targeting Capability. Bioengineering. 2023; 10(7):748. https://doi.org/10.3390/bioengineering10070748
Chicago/Turabian StyleWang, Bo, Sen Chen, Xuyang Sun, Xiaohui Shan, Xiyu Zhu, Bo Yuan, Hongzhang Wang, Gang Zhou, and Jing Liu. 2023. "A Photothermally Enhanced Vancomycin-Coated Liquid Metal Antimicrobial Agent with Targeting Capability" Bioengineering 10, no. 7: 748. https://doi.org/10.3390/bioengineering10070748
APA StyleWang, B., Chen, S., Sun, X., Shan, X., Zhu, X., Yuan, B., Wang, H., Zhou, G., & Liu, J. (2023). A Photothermally Enhanced Vancomycin-Coated Liquid Metal Antimicrobial Agent with Targeting Capability. Bioengineering, 10(7), 748. https://doi.org/10.3390/bioengineering10070748

